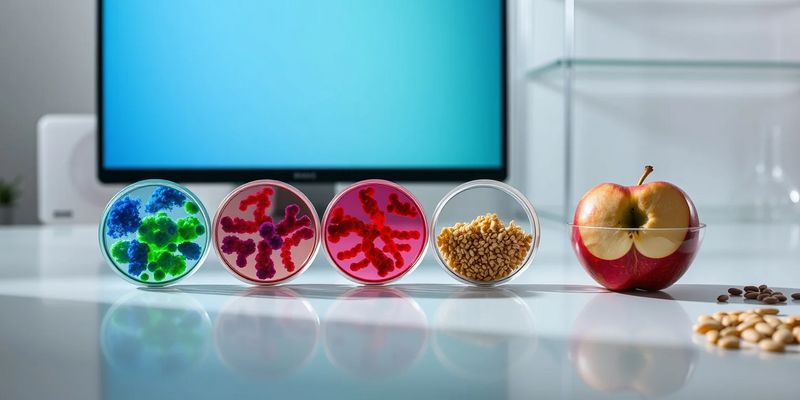
Darmbakterien entscheiden: Warum Ihr Mittagessen anders wirkt als meins - Foto: über boerse-global.de

Darmbakterien entscheiden: Warum Ihr Mittagessen anders wirkt als meins
03.12.2025 - 22:40:12Neue Daten aus dem Jahr 2025 bestätigen: Die Reaktion auf Nahrungsmittel ist so einzigartig wie ein Fingerabdruck. Aktuelle Studien des NIH und führender Forschungsinstitute zeigen, warum Kalorienzählen allein oft scheitert und wie die innere Uhr unserer Bakterien den Stoffwechsel steuert.
Während sich die Welt auf die festliche Jahreszeit vorbereitet und die Diskussionen um Kalorienbomben und Neujahrsvorsätze wieder aufflammen, liefert die Wissenschaft eine beruhigende, aber auch komplexe Botschaft: Es liegt nicht nur an Ihrer Willenskraft, wenn die Pfunde bleiben. Es liegt an Ihren Bakterien.
Neue Erkenntnisse aus dem laufenden “Nutrition for Precision Health”-Programm (NPH) der US-National Institutes of Health und aktuelle Veröffentlichungen in eBioMedicine und Nature Medicine markieren das endgültige Ende der “Diät für alle”. Die Kernbotschaft: Ein Lebensmittel, das für den einen “Medizin” ist, kann für den anderen metabolischen Stress bedeuten.
Lange galt die Annahme, dass ein Apfel oder eine Scheibe Vollkornbrot bei jedem Menschen die gleiche Blutzuckerreaktion auslöst. Diese These ist nun widerlegt. Aktuelle Analysen zeigen, dass die Blutzuckerantwort nach dem Essen drastisch variiert – und der Hauptakteur dabei ist das Darmmikrobiom.
Passend zum Thema Mikrobiom und individuelle Stoffwechselantworten: Viele Menschen interpretieren Blutzucker-, Cholesterin- oder TSH-Werte falsch – gerade wenn es um personalisierte Ernährung geht. Der kostenlose 25‑seitige Report “Laborwerte‑Selbstcheck” erklärt verständlich, welche Laborwerte wirklich wichtig sind, wie Sie Ergebnisse richtig einordnen und wann präzisere Spezialtests sinnvoll sind. Ideal für alle, die ihre Ernährungsstrategie auf echte Messwerte stützen wollen. Gratis Laborwerte-Report jetzt sichern
Eine wegweisende Studie in eBioMedicine untersuchte die Interaktion zwischen Darmbakterien und kohlenhydratreichen Diäten. Das Ergebnis: Spezifische mikrobielle Signaturen können vorhersagen, ob eine Person auf eine kohlenhydratreiche Ernährung mit stabilen oder extrem schwankenden Blutzuckerwerten reagiert.
Menschen mit einer Dominanz bestimmter Bakterienstämme wie Bacteroidetes verstoffwechseln Kohlenhydrate völlig anders als jene mit Firmicutes-Dominanz. Konkret: Für Person A könnte die Banane der perfekte Snack sein, während sie bei Person B einen Blutzuckerspike verursacht, der Heißhunger und Fetteinlagerung begünstigt.
Die innere Uhr der Bakterien: Timing ist alles
Eine der spannendsten Entwicklungen ist die Verknüpfung von Chronobiologie und Mikrobiom. Forschungsergebnisse der University of California, Irvine, und des Pacific Northwest National Laboratory haben gezeigt: Unsere Darmbakterien haben ihren eigenen zirkadianen Rhythmus.
Diese “bakterielle Uhr” muss mit der inneren Uhr des Wirts synchron laufen. Essen wir spät abends, treffen die Nährstoffe auf ein Mikrobiom im “Ruhemodus”. Die Folgen:
- Verschlechterte Glukosetoleranz
- Erhöhte Entzündungswerte
- Störung der Darmbarriere
Diese Erkenntnis erklärt, warum Schichtarbeiter und “Late-Night-Snacker” ein signifikant höheres Risiko für Typ-2-Diabetes haben – selbst bei gleicher Kalorienmenge. Die Frage ist nicht mehr nur was wir essen, sondern wann wir es unseren Mikroben servieren.
Das “Moonshot”-Projekt der Ernährungswissenschaft
Um diese individuellen Unterschiede vorhersagbar zu machen, läuft derzeit das bisher größte Forschungsprojekt seiner Art: Die “Nutrition for Precision Health”-Studie der NIH.
Mit einem Budget von über 170 Millionen Dollar und tausenden aktiven Teilnehmern zielt das Projekt darauf ab, Algorithmen zu entwickeln, die individuelle Reaktionen auf Lebensmittel präzise vorhersagen. Die Teilnehmer durchlaufen verschiedene Module – von der Datenerfassung mittels Wearables und Stuhlproben bis hin zu streng kontrollierten Ernährungsphasen in Kliniken.
Erste Datensätze bestätigen: Eine Kombination aus Genetik, Mikrobiom, Stoffwechselprofil und Umweltfaktoren ist notwendig, um eine wirklich “gesunde” Ernährung zu definieren. KI-gestützte Modelle beginnen nun, diese komplexen Datenmengen zu entwirren.
Ein Markt im Wandel
Die wissenschaftlichen Durchbrüche wirken sich massiv auf die Ernährungsindustrie aus. Der Markt für personalisierte Ernährung erreicht laut Statista-Prognosen ein Volumen von über 16 Milliarden Dollar.
Unternehmen wie ZOE oder DayTwo haben den Weg bereitet, indem sie kontinuierliche Glukosemessung und Mikrobiom-Analysen für Endverbraucher zugänglich machten. Der Trend geht tiefer: Weg von reinen Lifestyle-Produkten hin zu evidenzbasierten medizinischen Anwendungen.
Branchenexperten sehen zwei Haupttrends:
- Metabolische Phänotypisierung: Patienten erhalten zunehmend Profile ihres Stoffwechseltyps statt allgemeiner Diätpläne
- Mikrobiom-Modulation: Entwicklung von “Präzisions-Präbiotika”, die gezielt fehlende Bakterien füttern
Kritiker mahnen jedoch zur Vorsicht: Während die Wissenschaft rasant fortschreitet, hinkt die Regulierung hinterher. Nicht jeder Online-Test basiert auf den validierten Standards der aktuellen Studien.
Der Algorithmus auf dem Teller
Die Ära der Ernährungspyramide, die für alle gleich aussieht, nähert sich ihrem Ende. Wir bewegen uns auf eine Zukunft zu, in der eine App uns morgens mitteilt, ob heute Haferflocken oder Rührei die metabolisch klügere Wahl sind.
Für 2026 erwarten Experten die ersten Ergebnisse der kontrollierten Fütterungsstudien des NIH, die den “Goldstandard” für personalisierte Ernährungsempfehlungen definieren könnten. Bis dahin bleibt der beste Rat: Hören Sie auf Ihren Körper – und denken Sie daran, dass Sie nie alleine essen. Sie füttern immer Billionen von mikroskopischen Mitbewohnern mit.
PS: Wollen Sie vor Arztterminen oder Ernährungsumstellungen besser vorbereitet sein? Der “Laborwerte‑Selbstcheck” liefert praxisnahe Erklärungen zu TSH, Glukose, Cholesterin & Co., zeigt, welche Befunde wirklich relevant sind, und gibt Hinweise auf sinnvolle Spezialtests. Der 25‑seitige PDF‑Report ist kostenlos und hilft Ihnen, Messergebnisse mit Ihrer personalisierten Ernährungsstrategie in Einklang zu bringen. Laborwerte-Guide kostenlos herunterladen